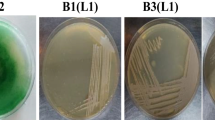

Abstract
Huge discharge of different organic and inorganic waste compounds into water sources is the prime reason for water pollution. To protect the environment, appropriate biological treatment methods of wastewater with high removal efficacy are needed. To meet this end, indigenously available microbial consortiums were explored for their possible bioremediation efficiency. Cyanobacteria purified from microbial consortium was identified as Desertifilum sp. based on 16 s rRNA gene sequencing, and its biochemical characteristics were determined. High-rate algal pond (HRAP) of 6 m3 volume with dimensions of 3 m × 2 m × 1 m was inoculated @ 0.25% and operated in an open environment at a light intensity of 38,000 to 62,000 lx with a hydraulic retention time (HRT) of 12 days. Results obtained after 12 days showed removal efficiencies of 78.26, 76, 79.55, 4.77, and 58.74% for soluble chemical oxygen demand (sCOD), total chemical oxygen demand (tCOD), biochemical oxygen demand (BOD), nitrates, and total phosphorus, respectively. The results from the study inferred that Desertifilum sp. is a suitable candidate for secondary-stage wastewater treatment without any additional amendment. Moreover, the biochemical composition of the biomass obtained unraveled its potential application in the field of nutraceuticals.
Similar content being viewed by others
Explore related subjects
Discover the latest articles, news and stories from top researchers in related subjects.Avoid common mistakes on your manuscript.
1 Introduction
Urbanization and industrialization have generated tons of solid wastes and wastewater which affect the ecosystem’s stability and cause soil, water, and air pollution. Eutrophication-like problems are caused by nutrient enrichment of water bodies due to the dumping of untreated or partially treated wastewater in nearby rivers or streams (Mahapatra et al., 2013). To remove nutrients from wastewater, several chemical treatments and conventional physical methods are used. However, high cost, excessive generation of greenhouse gases (GHGs), and more sludge production are the major disadvantages limiting their use (Zhang et al., 2019). Moreover, through physical and chemical processes, contaminants and pollutants in wastewater are not fully removed from wastewater.
Microalgae are unicellular or simple multicellular, microscopic (2–200 µm), photosynthetic microorganisms that can thrive in harsh conditions and can grow autotrophically as well as mixotrophically (Daneshvar et al., 2019). Microalgae as well as cyanobacteria metabolize nitrogen, phosphorus, and carbon present in wastewater and can help in the potential treatment of wastewater. The microalgae-bacterial process works on self-synchronized microalgal photosynthesis and bacterial respiration. In this process, microalgae can effectively assimilate carbon dioxide and nutrients to generate oxygen, which is in turn utilized by bacteria for organic oxidation to produce carbon dioxide. They also sequester carbon dioxide from the environment and, hence, contribute to a reduction in the greenhouse effect (Ramanan et al., 2016). Microalgae-bacterial consortium-mediated bioremediation of domestic wastewater is supported by complex nutritional and metabolic interaction between microalgae and associated bacteria (Nagarajan et al., 2022). Cyanobacteria can be used either as monoculture or in symbiosis with other microbial populations for the treatment of wastewater. Microbial consortia are one of the most important types of symbiosis used for wastewater treatment. Each microbial population in consortia maintains cooperative interactions with each other by metabolite exchange leading to enhanced nutrient reduction potencies (Gonçalves et al., 2017).
Punjab is a state of agriculture with a total geographical area covered of 50,362 km2 and is located between 29°33′–32°32′N latitudes and 73°55′–76°51′E longitudes (Baweja et al., 2017). Most of the crops cultivated in Punjab are irrigated using groundwater. Excessive use of these groundwater sources has caused a serious threat to sustainable agriculture development (Sidhu et al., 2010). Many ponds and lakes existing in Punjab’s villages are severely polluted due to improper sanitation practices by nearby dwellers. Hence, to address the distressing rate of water decline in Punjab, it becomes inevitable to recycle and reuse wastewater generated from sewage treatment plants (STP) and village ponds. Most developing countries employ only secondary levels of wastewater treatment which does not address nutrient removal from wastewater efficiently as effluent-treated water still contains a vast amount of nutrients such as phosphorus and nitrogen (Cai et al., 2013). Hence, alternative methods that are economical and eco-friendly are needed for efficient wastewater management practices and nutrient removal from wastewater within permissible limits before its discharge.
The use of wastewater for the cultivation of cyanobacteria has several potential benefits such as minimizing freshwater use, reducing the extra cost of nutrient addition, removing nitrogen and phosphorus from wastewater, producing microalgal biomass as bioresources for biofuel or high-value by-products, and reducing investment and operating costs as compared to conventional chemical and mechanical wastewater treatments. Moreover, harvested microalgal biomass from wastewater treatment can be used to produce high-value by-products viz., bioethanol, biodiesel, biogas, etc.
Unlike our research, many studies are conducted with purified microalgal strains. Strains like Chlorella vulgaris, Chlorella variabiilis, Botryococcus braunii, Nitzschia sp., and Nannochloropsis sp. were explored for their bioremediation potential and additional value-added products (Alibas et al., 2023). But the potential of indigenous consortia is least explored especially in the ambient environmental conditions. Many researchers supported the integration of the microalgal process as a successful secondary wastewater treatment process. Most of the research carried out in the field of microalgae-bacterial-mediated wastewater treatment is performed in photobioreactors in controlled environmental conditions.
To meet this end, the present investigation was carried out to evaluate the potential of microbial consortium for the treatment of wastewater at a pilot scale with possible potential target application of biomass.
2 Material and Methods
The wastewater was collected from the sewage treatment plant of the Thapar Institute of Engineering and Technology, Patiala, Punjab after the primary treatment. The physicochemical behavior of wastewater has been characterized.
2.1 Collection and Cultivation of Consortium
The selective microbial consortium under study was collected from a wastewater pond in the village of Haripur district of Jalandhar, Punjab, India. The geographical location of the village wastewater pond is 30°22′42.23″ N and 76°20′40.01″ E with an altitude of 223 m. The climatic conditions of Patiala are semi-arid, and the average annual rainfall is 698.0 ± 297.3 mm. The consortium is cultivated in BG-11 media at 10% (v/v) with a 14:10 photoperiod cycle at 24 ± 2 °C for 8 days. The aeration was provided continuously at 1.5 LPM (liter per minute) at a light intensity of 12,000 lx.
2.2 Experimental Setup for Pilot-Scale Wastewater Treatment
The study was carried out in a high-rate algal pond of 6000 L (6 m3) with dimensions of 3 m × 2 m × 1 m. The working volume was kept at 4800 L. The experiment was conducted in an ambient environment under variable natural sunlight intensity ranges between 38,000 and 62,000 lx with a hydraulic retention time of 12 days. After 12 days of treatment, biomass was harvested, filtered using fine sieve mesh, dried, and finally weighed.
2.3 Purification of Dominant Microalgae Strain with Effective Wastewater Treatment Efficacy from Indigenous Microbial Consortium
The dominant microalgae strain was isolated from a pre-assessed indigenous consortium at the Department of Microbiology, Punjab Agricultural University, Ludhiana, Punjab, India. Isolation was performed on BG-11 media with the light intensity of 8000 lx and selective light and dark cycle of 14:10 at 28 ± 2 °C.
2.4 Biochemical Characterization and Molecular Identification of Potential Isolate with Wastewater Treatment Efficacy
2.4.1 Biochemical Characterization
Chlorophyll content was determined by the method of El-Baky et al. (2008) with little modifications. The method of DuBois et al. (1956) was used to determine carbohydrates. The lipids were estimated by sulfo-phospho-vanillin (SPV) assay given by Mishra et al. (2014). Proteins were estimated according to Lowry et al. (1951). The total phenolic content was quantified using Folin Ciocalteu’s method as described by Taga et al. (1984). Total antioxidant activity was measured by the method of Prieto et al. (1999). Screening of phytochemicals viz. quinones, saponins, and terpenoids was also performed (Tyagi, 2017).
2.4.2 Molecular Identification
Molecular identification of the isolate was done at the National Chemical Laboratory, NCIM, Pune. The biomass was harvested at the logarithmic growth phase. Extraction of Genomic DNA was done by employing the HiPurA Fungal DNA purification spin column kit (MB543-250PR, HiMedia, India). PCR amplification was carried out by using cyanobacterial specific 16SrRNA gene (1000 bp) primers, i.e., cya106F (5′CGG ACG GGT GAG TAA CGC GTG A 3′) and cya1281R (5′ GCA ATT ACT AGC GAT TCC TCC 3′) (Nübel et al., 1997). The PCR reaction was performed in 25-μL volume containing 10 μL EmeraldAmp GT PCR Master Mix, 2x (Takara Bio USA), 1 μL DNA template (50–100 ng), 1.25 μL (10 μM) of each primer (forward and reverse), and 11.5 μL of free-nuclease water using Applied Biosystems Veriti Thermal Cycler. The specifications of the PCR reaction were as follows: Initial denaturation at 94 °C for 5 min followed by 35 cycles of 94 °C for 1 min, 60 °C for 1 min, and 72 °C for 1 min and a final extension at 72 °C for 10 min. Detection of PCR products was done by staining with GelRed Nucleic Acid Gel Stain on 1% agarose electrophoresis gel in (1X) TBE buffer. Amplified products were visualized under a UV transilluminator (Protein Simple Red Imager SA-1000). Final purification of the PCR product was done by using Exonuclease I and Shrimp Alkaline Phosphatase Purification Kit (New England Biolabs, Inc) and cycle sequenced using the BigDye Terminator v.3.1 Cycle Sequencing Kit (Applied Biosystems, USA) under following conditions: Denaturation at 96 °C (1 min) followed by 25 cycles of 96 °C (10 s), 50 °C (5 s), and 60 °C (4 min). Cycle-sequenced amplicons were further purified using sodium acetate ethanol method (Thermo Fisher Scientific), and sequencing reactions were run on a 3500xL Genetic Analyzer (Applied Biosystems, USA).
2.5 Phylogenetic Analysis
Sequencing files (.ab1) were edited using CHROMASLITE (version 1.5). Basic Local Alignment Search Tool (BLAST), search was carried out to find the closest culture sequence retrieved from the National Centre for Biotechnology Information (NCBI) database that finds regions of local similarity between sequences (Altschul et al., 1990). The phylogenetic tree was constructed by Mega11 software using the neighborhood joining method with 1000 bootstrap replicates. The sequence was submitted to the NCBI GenBank database, and an accession number was allotted.
2.6 Analytical Methods
Physico-chemical parameters of wastewater such as BOD, COD, nitrates, and phosphates were analyzed by following the standard protocols of APHA (2012). pH was measured using a Lab 860 pH meter (Schott, Germany).
2.7 Statistical Analysis
Experiments were performed in triplicates. Error bars in figures display mean ± standard deviation. Two-way analysis of variance (ANOVA) was performed for statistical analysis using IBM SPSS Statistics 22. Data were considered statistically significant at P < 0.001. The differences between the means were calculated using Tukey’s test at the 0.05 level of significance test employing IBM SPSS Statistics 22.
3 Result and Discussions
In the present study, the potential of the selective microbial consortium was evaluated for the reduction in various physicochemical parameters of domestic wastewater to explore its potential for reusing in agricultural irrigation. The efficiency of wastewater treatment is the function of several parameters such as the growth rate of cyanobacteria which further depends on the metabolism of micro-organisms present in the consortium and available nutrients, system operating conditions, and harvested biomass for nutrient removal (Olguín, 2003). Under nutrient stress conditions, microalgal growth tends to slow down and use the nutrients available for the production of lipids or carbohydrates (Rodolfi et al., 2009). Cyanobacteria can grow under autotrophic, heterotrophic, or mixotrophic conditions (Mata et al., 2010) which makes it most suitable for wastewater treatment.
3.1 Wastewater Treatment at Pilot Scale
The selective microbial consortium under study was cultivated in BG-11 medium at 10% (v/v) inoculum rate with a 14:10 photoperiod cycle at 24 ± 2 °C for 8 days. The grown microbial consortium was inoculated in the algal pond at 0.25% inoculum size. Light intensity and photoperiod regime along with temperature are the important operational factors for the microalgae culture system because they can affect the wastewater treatment system by altering the proportions of specific microalgal species in the consortium (Moondra et al., 2020). The initial pH of the wastewater was 7.18 ± 0.01. The concentration of total solids in STP water was 772 ± 0.11 mg/L. The total solid content of wastewater is constituted by the presence of compounds like carbonates, bicarbonates, chlorides, sulfate, phosphate, nitrate, Ca, Mg, Na, K, Mn, and organic matter (Sahana and Shirnalli 2018). BOD and COD of wastewater were observed around 122 ± 2.30 and 230 ± 7.35 mg/L, respectively. The COD content of wastewater in this study is higher than that of BOD. The COD value may be attributed to the presence of organic matter and inorganic matter in wastewater as COD is a measure of non-biodegradable organic matter in biologically treated industrial effluents (Malaviya & Rathore, 2001). Nitrates present in wastewater were 32.6 ± 0.80 mg/L, and total phosphorus was 14.2 ± 0.22 mg/L. Domestic wastewater contains pathogens, suspended solids, organic matter, and organic and inorganic nutrients (Al-Jalil, 2009). Therefore, to minimize the health hazards caused by these pollutants present in wastewater, it is necessary to bring down them to the permissible limits. Nitrate contamination in water bodies includes anthropogenic activities, chemical fertilizers, sewage, and landfill by domestic waste (Shrimali & Singh, 2001). Several industrial effluents like plastic, metal treatment, textile, plywood, household cleaning, and pharmaceuticals further increase the nitrate pollution in groundwater (Singh et al., 2006). Phosphate pollution in groundwater occurs through non-point sources such as the natural decomposition of rocks and minerals, agricultural runoff, erosion, sedimentation, animals, and by-point sources such as sewage effluents and industrial discharges (Singh, 2013).
3.2 Analysis of Physio-Chemical Parameters of Wastewater after Treatment
For sustaining microalgal growth, organic carbon, nitrates, and phosphates are required. Organic carbon is mineralized by cyanobacteria by consuming the dissolved oxygen in wastewater to fulfill their carbon and energy demands. This organic carbon is taken in the form of BOD and COD. BOD is defined as the capability of microorganisms to oxidize organic material into CO2 and water. Hence, BOD uses dissolved oxygen in water causing the death of waterbodies. The primary goal of wastewater treatment is BOD removal (Sarfraz et al., 2021).
Higher COD may be attributed to the higher organic matter in wastewater (Malaviya & Rathore, 2001). The reduction of COD content might be due to the inherent potential of microbes to utilize organic compounds as an energy source besides carbon dioxide (Hu et al., 2012).
In the present study, the maximum percent reduction in soluble COD is 78.26% (Fig. 2) and 76% total COD (76%) (Fig. 1) occurred after 12 days of treatment as compared to initial values of soluble COD and total COD of 153.33 and 233.33 mg/L, respectively. On the other hand, natural reduction was also observed in control without inocula addition, i.e., 48.70% in soluble COD and 30.57% in total COD after 12 days of treatment (Fig. 2). Our results are in agreement with Maza-Márquez et al. (2017) who recorded an 80.7 ± 9.7% COD removal efficiency of the microalgae-bacteria consortium consisting of microalgae Scenedesmus obliquus and Chlorella vulgaris and bacteria Raoultella terrigena and P. agglomerans in Olive-washing water at Pilot-scale Photobioreactor.
The rate of COD reduction during the initial phase was low due to the acclimatization phase of organisms in a new environment, and secondly, the carbon might be colloidal, gradually biodegradable material. Generally, carbon is the restricting variable when algae are used in sewage. However, the carbon requirement for algal photosynthesis is fulfilled by atmospheric CO2 if found insufficient (Su et al., 2011).
A similar rate of reduction in BOD was observed after 12 days of treatment. After 72 h of treatment, a 30.11% BOD reduction was achieved. A BOD reduction of 61.36% was observed after 7 days of treatment. However, a decrease in BOD reduction was found with a further increase in treatment days. Consequently, the present study reported a 79.55% maximum percentage reduction in BOD after 12 days of reduction. Control treatment resulted in a lower percentage reduction, i.e., 11.36% as compared to microbial consortium treatment after 12 days of treatment (Fig. 3). Natural wastewater treatment without inoculation was observed initially. However, with an increase in treatment days, the rate of BOD and COD reduction has slowed down as compared to wastewater inoculated with the consortium. Comparative results showed a significant difference between control and consortium treatment. Khemka and Saraf (2017a, 2017b) reported a 70% reduction in the BOD content of dairy wastewater after 15 days of treatment with Desertifilum tharense MSAK01.
The removal of dissolved organic compounds and their derivatives might be the reason behind the reduction of BOD levels (Kotteswari et al., 2012). Biological oxygen demand (BOD) is the measure of oxygen present in wastewater for utilization by microorganisms for breaking down decomposable organic matter into simpler substances. It is also an indicator of the amount of organic matter present in wastewater (Divya & Santhanam, 2018). Photosynthetic microbes during the wastewater treatment process build their bodily substances for growth and development by converting BOD and COD into carbon sources (Hadiyanto & Soestrisnanto, 2013).
The two utmost important macronutrients for microalgal growth are Nitrogen and Phosphorus. They are required for growth, nutrient content, enzyme functioning, biochemical processes, and cell integrity of plants. Ammonium (NH4+) and nitrate (NO3−) are two preferred forms of nitrogen used by plants. Deficiency of nitrogen harms crop productivity and growth, while excess nitrogen has detrimental effects on humans and causes groundwater contamination (Akao et al., 2021). A deficiency of phosphorus adversely affects chlorophyll synthesis, growth, and metabolism of cells because it is necessary for the functioning Calvin cycle and many phosphorylation syntheses (Liang et al., 2013), whereas a surplus amount of phosphorus can retard growth, cause leaf necrosis, and reduce the availability of zinc elements resulting in loss of nutritional elements and organic metabolites. Thus, nitrogen and phosphorus should be within permissible limits in water as well as in soil, because both excess and deficiency of these nutrients adversely affect living organisms.
After 12 days of treatment, phosphate content was reduced to 1.97 mg/L as compared to the initial concentration of phosphate, i.e., 4.77 mg/L in STP water, while in control, phosphate concentration was reduced to only 3.40 mg/L after 12 days of treatment as compared to the initial concentration of 4.87 mg/L on day 1. Reduction in the control was very low as compared to the wastewater treated with the microbial consortium (Fig. 4). According to the Food and Agriculture Organization, permissible limits of phosphorus in irrigation water are 0–2 mg L−1 (Ayers and Westcot, 1985). After microbial consortium treatment, the permissible limit of phosphorus has been achieved making treated water suitable for irrigation. Fito and Alemu (2019) reported a reduction of 59% in total phosphorus content of municipal wastewater after treatment with a consortium consisting of microalgae Chlorella sp., Chlamydomonas sp., Scenedesmus sp., and bacteria carried out in 1 L of bioreactors at batch scale. However, in the present study under natural conditions, a 58.74% reduction in total phosphorus was achieved.
The major problem for most wastewater sources is the higher concentration of nutrients, particularly the TN and TP concentrations, which require costly chemical-based treatments to remove them during wastewater treatment. The TN and TP concentrations range from 10 to 60 mg/L in municipal wastewater, > 1000 mg/L in agricultural effluent, and 500–600 mg/L in farm wastewater (Chiu et al., 2015). Photosynthetic microbes have an astounding ability to grow in wastewater and to efficiently consume nutrients and accumulate metals from wastewater which makes them an extremely attractive means for sustainable and low-cost wastewater treatment (Devi et al., 2012).
Total phosphorus is reduced owing to its consumption by microbes, because phosphorus is required by algae for sustaining its growth and development such as for the synthesis of algal biomass and other intracellular polyphosphate compounds, phospholipids, adenosine triphosphates (ATP), and nucleic acids which are generally assimilated as inorganic orthophosphate, primarily as H2PO4− or HPO42− (Ding et al., 2015). The phosphorus removal mechanism is more complex as compared to nitrates as it is commonly assimilated in the form of orthophosphate. It is also utilized for growth, nucleic acid synthesis, and value-added compounds like astaxanthin and polyunsaturated fatty acids. Algae do not always uptake phosphorus stoichiometrically. It is affected by factors like the physiology of algae, concentration of phosphorus, light intensity, pH, and temperature affect. Cell phosphorus concentration is inversely related to phosphorus uptake (Choi, 2014). Hence, the cellular concentration of phosphorus controls the kinetics of phosphorus uptake (Choi, 2016).
Similarly, nitrate reduction after treatment has followed a similar trend. After 12 days of treatment nitrates were reduced to 4.77 mg/L as compared to 13.63 mg/L. On the other hand, in the control treatment, nitrate reduction was very low after 12 days of treatment, and it displayed a decrease to only 7.17 mg/L as compared to the initial value (Fig. 4). According to the Food and Agriculture Organization, permissible limits of nitrates in irrigation water are < 5 mg L−1 (Ayers and Westcot, 1985). After microbial consortium treatment, the permissible limit of nitrates has been achieved making treated water suitable for irrigation. Huo et al. (2020) reported that wastewater produced after vinegar generation was treated with a consortium consisting of Chlorella sp. along with Bacillus firmus and Beijerinckia fluminensis and observed with 20% reduction in nitrate content after treatment.
Nitrogen reduction in wastewater is the result of several processes occurring simultaneously including nitrification, biomass uptake of nitrogen, ammonia stripping, and loss in the atmosphere (Lv et al., 2017). Protein synthesis in cyanobacteria requires nitrogen; hence, it is an essential element contributing to microalgal growth. Nitrate is a preferential form for utilization by algae, and algal cells contain 5–10% of it. Under nitrogen-deficient conditions in a culture medium, lipids and carbohydrates are synthesized (Voltolina et al., 2005).
Results of statistical analysis after 12 days of treatment showed that the pH of wastewater treated with microbial consortium increased significantly displaying a high increase in pH (8.74) as compared to day 1 where the pH was 7.03. Control treatment showed a similar trend with a pH increase from day 1 to day 12 ranging from 7.05 to 8.02 (Fig. 1). However, the pH increase in wastewater treated with the microbial consortium was higher than in the control. The increase in pH from day 1 to day 2 was attributed to microalgal growth and hence photosynthesis. Cyanobacteria take up dissolved CO2 in the water during the process of photosynthesis, then by the action of the enzyme carbonic anhydrase, bicarbonate is converted into CO2, releasing hydroxyl ions, leading to an increase in pH (Morales et al., 2018).
Elevated pH levels not only increase the microalga’s ability to assimilate nutrients by changing the available form of nutrients but also affect the cellular physiology of the microalgae-bacterial consortium (Kube et al., 2018). The increased pH content also helped in the significant reduction of ammonical nitrogen and phosphates through ammonia volatilization and phosphate precipitation, respectively. This further increases the overall efficiency of the wastewater treatment system by the removal of the suspended algae from the wastewater leading to optimal productivity of the microalgae-bacterial consortium (Moondra et al., 2020).
After 12 days, about 258.3 g g−1 dw of microalgal biomass was obtained. The obtained potential amount of biomass can have applications in the field of biofuel and nutraceutical production as determined by its biochemical composition.
The interaction between microalgae and bacteria in the context of wastewater treatment was observed and applied extensively in stabilization ponds with microalgal growth. Photosynthetic oxygenation provided by microalgal metabolism proved to be effective for organic matter removal by bacteria. The stabilizing ponds are termed ‘high-rate algal ponds’ which are low-cost and energy-efficient treatment systems. Typically, any wastewater treatment system that treats non-sterile or unsanitized wastewater with microalgae develops a microalgae-bacteria consortium. The microbial community in the consortium varies throughout the treatment period, depending on the nutrient availability. Microalgae and bacteria in consortium interact in a mutualistic manner. Bacteria act as natural mineralizers in wastewater treatment participating in the degradation of organic carbon in a dissimilatory manner releasing CO2. Algal photosynthesis assimilates nitrogen, phosphorus, and the CO2 released by bacteria as beneficial biomass. The major macronutrients in wastewater that can be removed by microalgal systems are carbon (dissolved organic carbon, and gaseous CO2 from industrial waste), nitrogen, and phosphorus. Organic carbon is assimilated into algal biomass by heterotrophic or mixotrophic growth. Degradation of organic carbon by symbiotic bacteria could provide CO2 for photosynthesis with algae (Ramanan et al., 2016).
3.3 Biochemical Characterization
Several types of antioxidants, bioactive compounds, and compounds with biological functions were synthesized by cyanobacteria as a result of either primary or secondary metabolism. Keeping this in mind, a study of the biochemical composition of the methanolic extract of isolate RP was done.
Microalgae extracts are complex mixtures of the compounds present in microalgal biomass such as polysaccharides, phenols, polyunsaturated fatty acids, proteins, pigments, vitamins, terpenoids sterols. The constitution of extracts varies with season, age, species, and other environmental factors. Microalgal bioactive compounds belong to various chemical groups such as tannins, alkaloids, glycosides, lignans, terpenoids, which show different solubilities in different solvents. The most commonly used solvents for extract preparation are benzene, chloroform, diethyl ether, ethyl acetate, ethanol, hexane, methanol, and distilled water (Patil & Kaliwal, 2019). In the present study, methanolic extract of dried biomass of microalgal isolate RP was prepared and used for the detection of biochemical components. Due to its aptness to extricate both polar as well as non-polar components from plant material, methanol was employed as a polar solvent for the extraction of bioactive molecules from microalgae (Ukwubile et al., 2019).
A wide variety of pigments are synthesized by microalgae sp. Pigments like β-carotene (β-Car), lutein, canthaxanthin, astaxanthin (Asx), and fucoxanthin (Fcx) are known to be produced by the microalgae such as Botryococcus braunii, Chlorella sp., Chlorococcum sp., Coelastrella striolata, Haematococcus pluvialis, Dunaliella salina, Nanochloropsis sp., Scenedesmus sp., Spirulina platensis (Vignaud et al., 2023). Results illustrated that the chlorophyll content of RP was 54.30 mg L−1. Pigment content varies in microalgae sp. In a previous study conducted by Grubišić et al. (2022) the total chlorophyll content of microalgae Tetraselmis sp. C6 and Picochlorum sp. D3 was 54.03 mg/100 g DW. Chlorophyll is the green pigment found in green algae and plants and has a role in several biological functions like induction of apoptosis cancer cells, and anti-mutagenic, and antioxidation properties (Hashem et al., 2021). Pigment chlorophyll has several biotechnological applications. For example, it may be used as a natural food colorant, deodorant, or as a component of dentifrice and skin care cosmetics. It also has antitumor and anti-inflammatory functions. Chlorophyll has been reported to reduce the severity of facial acne vulgaris lesions with minimal side effects, after photodynamic therapy (Song et al., 2014).
Different amounts of carbohydrates, proteins, and lipids are present in microalgal biomass. Lipids are the most energy-rich compound (37.6 kJg−1), followed by proteins and carbohydrates with an energy content of 16.7 kJg−1 and 15.7 kJg−1, respectively (Wilhelm & Jakob, 2011).
Proteins in isolate RP were 366.80 mg g−1 dw. Previous studies on cyanobacterial species such as Desertifilum tharense (Perendeci et al., 2019), Cyanothece sp. (Hotos et al., 2023), Nostoc sp. (PCC 7936) (Alvarez et al., 2021), and Arthrospira platensis (López-Rodríguez et al., 2021) showed the protein content of 281 mg/g, (28.1%), 343 mg/g (34.3%), 500 mg/g (50%), 369 mg/g (36.90%), respectively. Proteins found in algae contain essential amino acids, and they are alike other protein sources, e.g., soybean and egg and have several benefits over traditional protein sources in terms of nutritional quality (Bleakley and Hayes., 2017).
RP showed a carbohydrate content of 80.22 mg g−1 dw. Our results are in agreement with Reitan et al. (2021) who showed that the total carbohydrate content in the microalgae varied from 54 mg g−1 DW in Tisochrysis lutea to 235 mg g−1 DW in Chaetoceros muelleri. Carbohydrates present are easy to digest and good for diabetic patients because they are cellulose and sugar-free (da Silva Braga et al., 2018). Carbohydrates present in microalgal biomass have the lowest energy content as compared to other organic groups, i.e., lipids and proteins, but they are preferred substrates for biofuel production such as bioethanol, biobutanol, biohydrogen. Depending on the type of species and cultivation conditions, the carbohydrate content of microalgal biomass varies. For instance, the carbohydrate content of Porphyridium cruentum and Spirogyra sp. ranges from 40 to 57% and 33 to 64%, respectively (Harun et al., 2010).
The lipid content found in the RP isolate was 79.83 mg g−1 dw. Previous studies reported the lipid content of 64 mg/g (6.4%), 190 mg/g (19%), 65.5 mg/g (6.55%), 60–110 mg/g (6–11%) in Chrysotila pseudoroscoffensis (Moreira et al., 2022), Desertifilum sp. (IPPASB-1220) (Bolatkhan et al., 2020), Nostoc calcicole (Nagappan et al., 2020), Synecoccus sp. (Singh and Kumar, 2022), respectively. Microalgal lipids are polar membrane lipids, i.e., phospholipids and glycolipids and non-polar lipids, i.e., triacylglycerols, glycerides, carotenoids (Ryckebosch et al., 2014). Lipid production is a function of many factors such as light conditions, temperature and nitrogen concentration, pH, and salt concentration (Zhu et al., 2016).
The total phenols present in biomass were calculated using the most precise Folin Ciocalteu method. Total phenols in isolate RP were 5.78 mg GAE g−1 dw. Jerez-Martel et al. (2017) reported that Euglena cantabrica contained 5.87 and 2.97 mg g−1 dry biomass of gallic and protocatechuic acids, respectively. Phenols are aromatic compounds that have a benzene ring with the –OH group attached as a functional group. In biological systems, phenolics have been associated with antioxidant activity and act as scavengers of singlet oxygen and free radicals. In plants, phenolic acids, flavonoids, and tannins are prime compounds that were contemplated as responsible for the antioxidant capacity. A variety of biological functions are performed by these antioxidants, e.g., anti-atherosclerotic, anti-inflammatory, and anti-carcinogenic activities (Patil & Kaliwal, 2019).
Total antioxidants in RP were 9.47 mg AAE g−1. High levels of antioxidant activity detected in isolate RP can be due to the presence of functional groups such as hydroxyl groups of phenols. Phenolic compounds have high redox potential which plays a pivotal role in the adsorption of free radicals and, thus, quench the O−1 and O−3 radicals. Phlorotannins are polyphenols that act as major antioxidants and help in resisting oxidative stress. Other functions are also performed by polyphenols. Polyphenol-enriched methanolic extracts of Ecklonia stolinifera significantly decreased the plasma glucose concentration and thus showed high anti-diabetic activity in Diabetes Mellitus-induced rats. Further, total polyphenols also play a significant role in the determination of the antiproliferative activity of algae (Thomas & Kim, 2011).
Phytochemical analysis of methanolic extracts of isolate RP indicated the presence of terpenoids and quinones while saponins were absent. Patil and Kaliwal (2019) observed the presence of alkaloids, saponins, glycosides, flavonoids, phenols, anthraquinones, and oils and fats in chloroform, acetone, ethanol, methanol, and aqueous extracts of microalgae Scenedesmus bajacalifornicus BBKLP-07.
3.4 Molecular Identification and Phylogenetic Analysis
Dominating photosynthetic isolate in the indigenous microbial consortium was purified on BG-11 Medium by the repeated sub-culturing method. The purified culture, i.e., RP was observed under a light microscope. Cells were non-branching filamentous with green or bright blue-green in color. The filaments have apical ends and were present alone or organized in separate bundles. Then, the purified culture, i.e., RP was sent to the National Chemical Laboratory, National Collection of Industrial Microorganisms (NCIM), Pune, India for molecular identification. The strain showed a close resemblance with Desertifilum sp. as shown by the phylogenetic tree (Fig. 1). The sequences were submitted to the NCIM GenBank database, and the following Accession number, i.e., OM832588 was obtained. Desertifilum sp. is an oscillatorean cyanobacterium with several potential applications. Desertifilum IPPAS B-1220 was used to fabricate silver nanoparticles that have anticancer and antibacterial activity against different cancer cell lines and pathogenic bacterial strains (Hamida et al., 2020). In another study conducted by Khazi et al. (2021), Desertifilum sp. has been characterized for c-phycocyanin production. Khemka and Saraf (2017a, 2017b) reported D. tharense as a potential strain for the treatment of dairy wastewater along with the production of lipids, protein, and carbohydrates.
4 Conclusion
It can be concluded that cyanobacteria RP isolated from a village wastewater pond of the Haripur district of Jalandhar (Punjab) was identified as a member of Desertifilum sp. The cyanobacteria were able to use contaminants present in wastewater to meet its growth requirement. Wastewater treatment by cyanobacteria can be employed either as a secondary or tertiary treatment and hence has the potential to treat wastewater at a pilot scale. Further, treated water has the potential to be used for irrigation purposes in agriculture.
Data Availability
The datasets used and analyzed during the current study are available within the article and its supplementary information files or from the corresponding author upon reasonable request.
References
Akao, P. K., Singh, B., Kaur, P., Sor, A., Avni, A., Dhir, A., Verma, S., Kapoor, S., Phutela, U. G., Satpute, S., Sharma, S., Avisar, D., Sandha, K. S., & Mamane, H. (2021). Coupled microalgal–bacterial biofilm for enhanced wastewater treatment without energy investment. Journal of Water Process Engineering, 41, 1–10. https://doi.org/10.1016/j.jwpe.2021.102029
Alibas, I., Yilmaz, A., Alibas, K., Arslan, M., & Koc, C. (2023). The effect of different drying methods and microalgae species on the quality parameters of biodiesel obtained by transesterification technique. Biomass and Bioenergy, 168, 106688. https://doi.org/10.1016/j.biombioe.2022.106688
Al-Jalil, S. A. (2009). COD and BOD reduction of domestic wastewater using activated sludge, sand filters and activated carbon in Saudi Arabia. Biotechnology, 8, 473–477. https://doi.org/10.3923/biotech.2009.473.477
Altschul, S. F., Gish, W., Miller, W., Myers, E. W., & Lipman, D. J. (1990). Basic local alignment search tool. Journal of Molecular Biology, 215, 403–410. https://doi.org/10.1016/S0022-2836(05)80360-2
Alvarez, X., Alves, A., Ribeiro, M. P., Lazzari, M., Coutinho, P., & Otero, A. (2021). Biochemical characterization of Nostoc sp. exopolysaccharides and evaluation of potential use in wound healing. Carbohydrate Polymers, 254, 117303. https://doi.org/10.1016/j.carbpol.2020.117303
APHA. (2012). Standards methods for examinations of waste and wastewater (22nd ed.). American Public Health Association.
Ayers, R. S., & Westcot, D. W. (1985). Water quality for agriculture. FAO Irrigation and Drainage, Paper 29, Food and Agriculture Organization, Rome.
Baweja, S., Aggarwal, R., & Brar, M. (2017). Groundwater depletion in Punjab, India. Encyclopedia of Soil Science (3rd edn., pp. 1–5). https://doi.org/10.1081/E-ESS3-120052901
Bleakley, S., & Hayes, M. (2017). Algal proteins: Extraction, application, and challenges concerning production. Foods, 6, 1–34. https://doi.org/10.3390/foods6050033
Bolatkhan, K., Sadvakasova, A. K., Zayadan, B. K., Kakimova, A. B., Sarsekeyeva, F. K., Kossalbayev, B. D., Bozieva, A. M., Alwasel, S., & Allakhverdiev, S. I. (2020). Prospects for the creation of a waste-free technology for wastewater treatment and utilization of carbon dioxide based on cyanobacteria for biodiesel production. Journal of Biotechnology, 324, 162–170. https://doi.org/10.1016/j.jbiotec.2020.10.010
Cai, T., Park, S. Y., & Li, Y. (2013). Nutrient recovery from wastewater streams by microalgae: Status and prospects. Renewable and Sustainable Energy Reviews, 19, 360–369. https://doi.org/10.1016/j.rser.2012.11.030
Chiu, S. Y., Kao, C. Y., Chen, T. Y., Chang, Y. B., Kuo, C. M., & Lin, C. S. (2015). Cultivation of microalgal Chlorella for biomass and lipid production using wastewater as nutrient resource. Bioresource Technology, 184, 179–189. https://doi.org/10.1016/j.biortech.2014.11.080
Choi, H. J. (2014). Effect of optical panel distance in a photobioreactor for nutrient removal and cultivation of microalgae. World Journal of Microbiology and Biotechnology, 30, 2015–2023. https://doi.org/10.1007/s11274-014-1626-z
Choi, H.-J. (2016). Dairy wastewater treatment using microalgae for potential biodiesel application. Environmental Engineering Research, 21, 393–400. https://doi.org/10.4491/eer.2015.151
da Silva Braga, V., da Silveira Mastrantonio, D. J., Costa, J. A. V., & de Morais, M. G. (2018). Cultivation strategy to stimulate high carbohydrate content in Spirulina biomass. Bioresource Technology, 269, 221–226. https://doi.org/10.1016/j.biortech.2018.08.105
Daneshvar, E., Zarrinmehr, M. J., Koutra, E., Karnaros, M., Farhadian, O., & Bhatnagar, A. (2019). Sequential cultivation of microalgae in raw and recycled dairy wastewater: Microalgal growth, wastewater treatment and biochemical composition. Bioresource Technology, 273, 556–564. https://doi.org/10.1016/j.biortech.2018.11.059
Devi, M. P., Subhash, G. V., & Mohan, S. V. (2012). Heterotrophic cultivation of mixed microalgae for lipid accumulation and wastewater treatment during sequential growth and starvation phases: Effect of nutrient supplementation. Renewable Energy, 43, 276–283. https://doi.org/10.1016/j.renene.2011.11.021
Ding, J., Zhao, F., Cao, Y., Xing, L., Liu, W., Mei, S., & Li, S. (2015). Cultivation of microalgae in dairy farm wastewater without sterilization. International Journal of Phytoremediation, 17, 222–27. https://doi.org/10.1080/15226514.2013.876970
Divya, M., & Santhanam, P. (2019). Bioremediation of wastewater using a novel method of microalgae immobilized on twin-layer recirculation system (TLRS). In P. Santhanam, A. Begum, & P. Pachiappan (eds.), Basic and Applied Phytoplankton Biology. Springer, Singapore. https://doi.org/10.1007/978-981-10-7938-2_8
DuBois, M., Gilles, K. A., Hamilton, J. K., Rebers, P. A., & Smith, F. (1956). Colorimetric method for determination of sugars and related substances. Analytical Chemistry, 28, 350–356. https://doi.org/10.1038/168167a0
El-Baky, H. H. A., El-Baz, F. K., & El-Baroty, G. S. (2008). Characterization of nutraceutical compounds in blue-green alga Spirulina maxima. Journal of Medicinal Plants Research, 2, 292–300.
Fito, J., & Alemu, K. (2019). Microalgae–bacteria consortium treatment technology for municipal wastewater management. Nanotechnology for Environmental Engineering, 4, 1–9. https://doi.org/10.1007/s41204-018-0050-2
Gonçalves, A. L., Pires, J. C., & Simões, M. (2017). A review on the use of microalgal consortia for wastewater treatment. Algal Research, 24, 403–415. https://doi.org/10.1016/j.algal.2016.11.008
Gonçalves, C. F., Menegol, T., & Rech, R. (2019). Biochemical composition of green microalgae Pseudoneochloris marina grown under different temperature and light conditions. Biocatalysis, 18, 1–10. https://doi.org/10.1016/j.bcab.2019.101032
Grubišić, M., Šantek, B., Zorić, Z., Čošić, Z., Vrana, I., Gašparović, B., Čož-Rakovac, R., & Šantek, M. I. (2022). Bioprospecting of microalgae isolated from the Adriatic Sea: Characterization of biomass, pigment, lipid and fatty acid composition, and antioxidant and antimicrobial activity. Molecules, 27, 1248. https://doi.org/10.3390/molecules27041248
Hadiyanto, C. M., & Soestrisnanto, D. (2013). Phytoremediation of palm oil mill effluent (POME) by using aquatic plants and microalgae for biomass production. Journal of Environmental Science and Technology, 6, 79–90. https://doi.org/10.5829/idosi.ije.2014.27.12c.02
Hamida, R. S., Abdelmeguid, N. E., Ali, M. A., Bin-Meferij, M. M., & Khalil, M. I. (2020). Synthesis of silver nanoparticles using a novel cyanobacteria Desertifilum sp. extract: Their antibacterial and cytotoxicity effects. International Journal of Nanomedicine, 15, 49–63. https://doi.org/10.2147/IJN.S238575
Harun, M. R., Singh, M., Forde, G., & Danquah, M. K. (2010). Bioprocess engineering of microalgae to produce a variety of consumer products. Renewable and Sustainable Energy Reviews, 14(3), 1037–1047. https://doi.org/10.1016/j.rser.2009.11.004
Hashem, S. M., El-Lahot, A., Helal, A. M., & Massoud, M. I. (2021). Evaluation of the phytochemicals and nutritional characteristics of some microalgae grown in Egypt as healthy food supplements. Egyptian Journal of Food Science, 49, 173–185. https://doi.org/10.21608/ejfs.2021.66232.1100
Hotos, G., Avramidou, D., Mastropetros, S. G., Tsigkou, K., Kouvara, K., Makridis, P., & Kornaros, M. (2023). Isolation, identification, and chemical composition analysis of nine microalgal and cyanobacterial species isolated in lagoons of Western Greece. Algal Research, 69, 102935. https://doi.org/10.1016/j.algal.2022.102935
Hu, B., Min, M., Zhou, W., Li, Y., Mohr, M., Cheng, Y., Lei, H., Liu, Y., Lin, X., Chen, P., & Ruan, R. (2012). Influence of exogenous CO2 on biomass and lipid accumulation of microalgae Auxenochlorella protothecoides cultivated in concentrated municipal wastewater. Applied Biochemistry and Biotechnology, 166, 1661–1673. https://doi.org/10.1007/s12010-012-9566-2
Huo, S., Kong, M., Zhu, F., Qian, J., Huang, D., Chen, P., & Ruan, R. (2020). Co-culture of Chlorella and wastewater-borne bacteria in vinegar production wastewater: Enhancement of nutrients removal and influence of algal biomass generation. Algal Research, 45, 101744. https://doi.org/10.1016/j.algal.2019.101744
Jerez-Martel, I., García-Poza, S., Rodríguez-Martel, G., Rico, M., Afonso-Olivares, C., & Gómez-Pinchetti, J. (2017). Phenolic profile and antioxidant activity of crude extracts from microalgae and cyanobacteria strains. Journal of Food Quality, 4, 1–8. https://doi.org/10.1155/2017/2924508
Khazi, M. I., Li, C., Liaqat, F., Malec, P., Li, J., & Fu, P. (2021). Acclimation and characterization of marine cyanobacterial strains Euryhalinema and Desertifilum for C-phycocyanin production. Frontiers in Bioengineering and Biotechnology, 9, 1–13. https://doi.org/10.3389/fbioe.2021.752024
Khemka, A., & Saraf, M. (2017). Strategic enhancement of Desertifilum tharense MSAK01 on dairy wastewater: An integrated approach for remediation and biomass production. 7, 2779–27785.Applied Water Science, 7:1–7. https://doi.org/10.1007/s13201-017-0525-5
Khemka, A., & Saraf, M. (2017a). Strategic enhancement of Desertifilum tharense MSAK01 on dairy wastewater: An integrated approach for remediation and biomass production. Applied Water Science, 7, 2779–2785. https://doi.org/10.1007/s13201-017-0525-5
Kotteswari, M., Murugesan, S., & Ranjith Kumar, R. (2012). Phycoremediation of dairy effluent by using the microalgae Nostoc sp. International Journal of Environmental Research and Development, 2, 35–43.
Kube, M., Jefferson, B., Fan, L., & Roddick, F. (2018). The impact of wastewater characteristics, algal species selection and immobilisation on simultaneous nitrogen and phosphorus removal. Algal Research, 31, 478–488. https://doi.org/10.1016/j.algal.2018.01.009
Liang, K., Zhang, Q., Gu, M., & Cong, W. (2013). Effect of phosphorus on lipid accumulation in freshwater microalgae Chlorella sp. Journal of Applied Phycology, 25, 311–318. https://doi.org/10.1007/s10811-012-9865-6
López-Rodríguez, A., Mayorga, J., Flaig, D., Fuentes, G., Cotabarren, J., Obregón, W. D., & Gómez, P. I. (2021). Comparison of two strains of the edible cyanobacteria Arthrospira: Biochemical characterization and antioxidant properties. Food Bioscience, 42, 101144. https://doi.org/10.1016/j.fbio.2021.101144
Lowry, O. H., Rosebrough, N. J., Farr, A. L., & Randall, R. J. (1951). Protein measurement with folin-phenol reagent. Journal of Biological Chemistry, 193, 265–275. https://doi.org/10.1016/S0021-9258(19)52451-6
Lv, J., Feng, J., Liu, Q., & Xie, S. (2017). Microalgal cultivation in secondary effluent: Recent developments and future work. International Journal of Molecular Sciences, 18, 79–94. https://doi.org/10.3390/ijms18010079
Mahapatra, D. M., Chanakya, H. N., & Ramachandra, T. V. (2013). Treatment efficacy of algae-based sewage treatment plants. Environmental Monitoring and Assessment, 185, 7145–7164. https://doi.org/10.1007/s10661-013-3090-x
Malaviya, P., & Rathore, V. S. (2001). A correlation study on some physicochemical quality parameters of pulp and paper mill effluents. Pollution Research, 20, 465–470.
Mata, T. M., Martins, A. A., & Caetano, N. S. (2010). Microalgae for biodiesel production and other applications. Renewable and Sustainable Energy Reviews, 14, 217–232. https://doi.org/10.1016/j.rser.2009.07.020
Maza-Márquez, P., González-Martínez, A., Martínez-Toledo, M. V., Fenice, M., Lasserrot, A., & González-López, J. (2017). Biotreatment of industrial olive washing water by synergetic association of microalgal-bacterial consortia in a photobioreactor. Environmental Science and Pollution Research, 24, 527–538. https://doi.org/10.1007/s11356-016-7753-3
Mishra, S. K., Suh, W. I., Farooq, W., Moon, M., Shrivastav, A., Park-Min, S., & Yang, J. W. (2014). Rapid quantification of microalgal lipids in aqueous medium by a simple colorimetric method. Bioresource Technology, 155, 330–333. https://doi.org/10.1016/j.biortech.2013.12.077
Moondra, N., Jariwala, N. D., & Christian, R. A. (2020). Microalgal-bacterial consortia: An alluring and novel approach for domestic wastewater treatment. Waste Conversion and Management, 4, 51–56. https://doi.org/10.26480/wcm.01.2020.51.56
Morales, M., Sanchez, L., & Revah, S. (2018). The impact of environmental factors on carbon dioxide fixation by microalgae. FEMS Microbiology Letters, 365, 1–11. https://doi.org/10.1093/femsle/fnx262
Moreira, A. S. P., Gonçalves, G., Conde, T. A., Couto, D., Melo, T., Maia, I. B., Pereira, H., Silva, J., Domingues, M. R., & Nunes, C. (2022). Chrysotila pseudoroscoffensis as a source of high-value polar lipids with antioxidant activity: A lipidomic approach. Algal Research, 66, 102756. https://doi.org/10.1016/j.algal.2022.102756
Nagappan, S., Bhosale, R., Duc Nguyen, D., Pugazhendhi, A., Tsai, P.-C., Chang, S. W., Ponnusamy, V. K., & Kumar, G. (2020). Nitrogen-fixing cyanobacteria as a potential resource for efficient biodiesel production. Fuel, 279, 118440. https://doi.org/10.1016/j.fuel.2020.118440
Nagarajan, D., Chen, C. Y., Ariyadasa, T. U., Lee, D. J., & Chang, J. S. (2022). Macroalgal biomass as a potential resource for lactic acid fermentation. Chemosphere, 309, 136694. https://doi.org/10.1016/j.chemosphere.2022.136694
Nübel, U., Garcia-Pichel, F., & Muyzer, G. (1997). PCR primers to amplify 16S rRNA genes from cyanobacteria. Applied and Environmental Microbiology, 63, 3327–3332. https://doi.org/10.1128/aem.63.8.3327-3332.1997
Olguín, E. J. (2003). Phycoremediation: Key issues for cost-effective nutrient removal processes. Biotechnological Advances, 22, 81–91. https://doi.org/10.1016/S0734-9750(03)00130-7
Patil, L., & Kaliwal, B. B. (2019). Microalga Scenedesmus bajacalifornicus BBKLP-07, a new source of bioactive compounds with in vitro pharmacological applications. Bioprocess and Biosystems Engineering. https://doi.org/10.1007/s00449-019-02099-5
Perendeci, N. A., Yılmaz, V., Tastan, B. E., Gökgöl, S., Fardinpoor, M., Namlı, A., & Steyer, J. P. (2019). Correlations between biochemical composition and biogas production during anaerobic digestion of microalgae and cyanobacteria isolated from different sources of Turkey. Bioresource Technology, 281, 209–216. https://doi.org/10.1016/j.biortech.2019.02.086
Prieto, P., Pineda, M., & Aguilar, M. (1999). Spectrophotometric quantitation of antioxidant capacity through the formation of a phosphomolybdenum complex: Specific application to the determination of vitamin E. Analytical Biochemistry, 269, 337–341. https://doi.org/10.1006/abio.1999.4019
Ramanan, R., Kim, B., Cho, D., Oh, H., & Kim, H. (2016). Algae bacteria interactions: Evolution, ecology and emerging applications. Biotechnology Advances, 34, 1–29. https://doi.org/10.1016/j.biotechadv.2015.12.003
Reitan, K. I., Øie, G., Jørgensen, H., & Wang, X. (2021). Chemical composition of selected marine microalgae, with emphasis on lipid and carbohydrate production for potential use as feed resources. Journal of Applied Phycology, 33, 3831–3842. https://doi.org/10.1007/s10811-021-02586-x
Rodolfi, L., Zittelli, G. C., Bassi, N., Padovani, G., Biondi, N., Bonini, G., & Tredici, M. R. (2009). Microalgae for oil: Strain selection, induction of lipid synthesis and outdoor mass cultivation in low-cost photobioreactor. Biotechnology and Bioengineering, 102, 100–112. https://doi.org/10.1002/bit.22033
Ryckebosch, E., Bruneel, C., Termote-Verhalle, R., Goiris, K., Muylaert, K., & Foubert, I. (2014). Nutritional evaluation of microalgae oils rich in omega-3 long chain polyunsaturated fatty acids as an alternative for fish oil. Food Chemistry, 160, 399–400. https://doi.org/10.1016/j.foodchem.2014.03.087
Sarfraz, R., Taneez, M., Sardar, S., Danish, L., & Hameed, A. (2021). Evaluation of Desmodesmus subspicatus for the treatment of wastewater. International Journal of Environmental and Analytical Chemistry, 103, 1–12. https://doi.org/10.1080/03067319.2021.1910681
Shrimali, M., & Singh, K. P. (2001). New methods of nitrate removal from water. Environmental Pollution, 112, 351–359. https://doi.org/10.1016/s0269-7491(00)00147-0
Sidhu, R. S., Vatta, K., & Dhaliwal, H. S. (2010). Conservation agriculture in Punjab: Economic implication of technologies and practices. Indian Journal of Agricultural Economics, 65, 413–427.
Singh, A. L. (2013). Nitrate and phosphate contamination in water and possible remedial measures. In Environmental Problems and Plant; Essay; Environmental Science, Department of Botany, Banaras Hindu University: Varanasi (pp. 44–51), India.
Singh, K. P., Singh, V. K., Malik, A., & Basant, N. (2006). Distribution of nitrogen species in groundwater aquifers of an industrial area in alluvial Indo-Gangetic plains: A case study. Environmental Geochemistry and Health, 28, 473–485. https://doi.org/10.1007/s10653-006-9053-1
Singh, P., & Kumar, D. (2022). Biomass and lipid production potential of cyanobacteria and microalgae isolated from the diverse habitats of Garhwal Himalaya, Uttarakhand. India. Biomass and Bioenergy, 162, 106469. https://doi.org/10.1016/j.biombioe.2022.106469
Song, B. H., Lee, D. H., Kim, B. C., Ku, S. H., Park, E. J., Kwon, I. H., Kim, K. H., & Kim, K. J. (2014). Photodynamic therapy using chlorophyll-a in the treatment of acne vulgaris: A randomized, single-blind, split face study. Journal of American Academy of Dermatology, 71, 764–771. https://doi.org/10.1016/j.jaad.2014.05.047
Su, Y., Mennerich, A., & Urban, B. (2011). Municipal wastewater treatment and biomass accumulation with a wastewater-born and settleable algal-bacterial culture. Water Research, 45, 3351–3358. https://doi.org/10.1016/j.watres.2011.03.046
Taga, M. S., Miller, E. E., & Pratt, D. E. (1984). Chia seeds as a source of natural lipid antioxidants. Journal of American Oil Chemists’ Society, 61, 928–931. https://doi.org/10.1007/BF02542169
Thomas, N. V., & Kim, S. K. (2011). Potential pharmacological applications of polyphenolic derivatives from marine brown algae. Environmental Toxicology and Pharmacology, 32, 325–335. https://doi.org/10.1016/j.etap.2011.09.004
Tyagi, T. (2017). Phytochemical screening of active metabolites present in Eichhornia crassipes (Mart.) Solms and Pistia Stratiotes (L.): Role in ethanomedicine. Asian Journal of Pharmaceutical Education and Research, 6, 40–56.
Ukwubile, C. A., Ahmed, A., Katsayal, U. A., Ya’u, J., & Mejida, S. (2019). GC–MS analysis of bioactive compounds from Melastomastrum capitatum (Vahl) Fern. leaf methanol extract: An anticancer plant. Scientific African, 3, 1–8. https://doi.org/10.1016/j.sciaf.2019.e00059
Vignaud, J., Loiseau, C., Herault, J., Mayer, C., Come, M., Martin, I., & Ulmann, I. (2023). Microalgae produce antioxidant molecules with potential preventive effects on mitochondrial functions and skeletal muscular oxidative stress. Antioxidants, 12, 1050. https://doi.org/10.3390/antiox12051050
Voltolina, D., Gómez-Villa, H., & Correa, G. (2005). Nitrogen removal and recycling by Scenedesmus obliquus in semicontinuous cultures using artificial wastewater and a simulated light and temperature cycle. Bioresource Technology, 96, 359–362. https://doi.org/10.1016/j.biortech.2004.04.004
Wilhelm, C., & Jakob, T. (2011). From photons to biomass and biofuels: Evaluation of different strategies for the improvement of algal biotechnology based on comparative energy balances. Applied Microbiology and Biotechnology, 92, 909–919. https://doi.org/10.1007/s00253-011-3627-2
Zhang, M., Gu, J., & Liu, Y. (2019). Engineering feasibility, economic viability and environmental sustainability of energy recovery from nitrous oxide in biological wastewater treatment plant. Bioresource Technology, 282, 514–519. https://doi.org/10.1016/j.biortech.2019.03.040
Zhu, L. D., Li, Z. H., & Hiltunen, E. (2016). Strategies for lipid production improvement in microalgae as a biodiesel feedstock. Biomed Research International, 2016, 1–8. https://doi.org/10.1155/2016/8792548
Funding
Funding was provided by the collaborative project of TIET-TAU Center of Excellence for Food Security (T2CEFS) under the Collaborative Project with PAU, “Enhanced Treatment of Wastewater using a Synergy of Microalgae and Microorganisms—Without Energy Investment and Biofuel Production”.
Author information
Authors and Affiliations
Contributions
BS: experimentation. AD: conceptualization and validation. NS: manuscript writing and data analysis. SGS, GSK, HM: review and editing.
Corresponding author
Ethics declarations
Conflict of Interest
The authors declare no competing interests.
Additional information
Publisher's Note
Springer Nature remains neutral with regard to jurisdictional claims in published maps and institutional affiliations.
Rights and permissions
Springer Nature or its licensor (e.g. a society or other partner) holds exclusive rights to this article under a publishing agreement with the author(s) or other rightsholder(s); author self-archiving of the accepted manuscript version of this article is solely governed by the terms of such publishing agreement and applicable law.
About this article
Cite this article
Singh, B., Sharma, N., Sharma, S.G. et al. Application of Microbial Consortium to the Pilot-Scale Treatment of Primary Treated Sewage Wastewater. Water Air Soil Pollut 235, 132 (2024). https://doi.org/10.1007/s11270-024-06953-5
Received:
Accepted:
Published:
DOI: https://doi.org/10.1007/s11270-024-06953-5